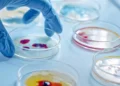

Τέλος η μάσκα στους εξωτερικούς χώρους από το Σάββατο, 5 Μαρτίου, σύμφωνα με το υπουργείο Υγείας.
Σήμερα Τετάρτη, 2 Μαρτίου, η Επιτροπή των Ειδικών συνεδρίαζε και είχε γίνει γνωστό ήδη πως οι λοιμωξιολόγοι έδωσαν το «πράσινο φως» για άρση της χρήσης μάσκας στους ανοιχτούς χώρους.
Σε συνέχεια λοιπόν, της συνεδρίασης της Επιτροπής, το υπουργείο ανακοίνωσε πως δεν είναι υποχρεωτική η χρήση μάσκας στους εξωτερικούς χώρους αν και παραμένει ως ισχυρή σύσταση η χρήση της σε ανοιχτούς χώρους με συνωστισμό καθώς και σε άτομα με παράγοντες κινδύνου για σοβαρή νόσο και ανεμβολίαστα άτομα.
Υπενθυμίζεται πως και στη συνεδρίαση της περασμένης εβδομάδας είχε τεθεί το ζήτημα της άρσης της χρήσης μάσκας στους εξωτερικούς χώρους αλλά η Επιτροπή δεν είχε δώσει το «πράσινο φως».
Η ανακοίνωση από το υπουργείο Υγείας για τις μάσκες
«Στη σημερινή συνεδρίαση της η Επιτροπή Εμπειρογνωμόνων υπό την Γενική Γραμματέα Δημόσιας Υγείας, Ειρήνη Αγαπηδάκη εισηγήθηκε την άρση της υποχρεωτικής χρήσης μάσκας στους εξωτερικούς χώρους. Παραμένει όμως, ως ισχυρή σύσταση η χρήση μάσκας σε εξωτερικούς χώρους με συνωστισμό καθώς και σε άτομα με παράγοντες κινδύνου για σοβαρή νόσο και ανεμβολίαστα άτομα.
Η εισήγηση της Επιτροπής γίνεται αποδεκτή από την Κυβέρνηση και οι λεπτομέρειες θα διευκρινίσουν στην υπό έκδοση ΚΥΑ. Τα νέα μέτρα θα τεθούν σε εφαρμογή από το Σάββατο 05.03.2022».